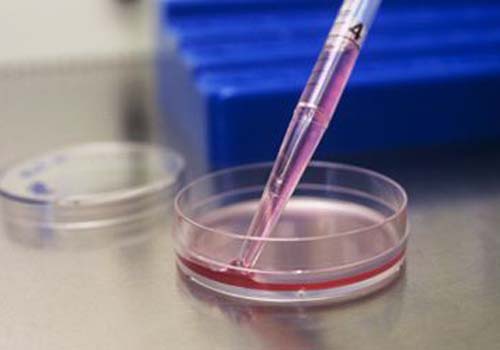
timg (3).jpg

美国试管婴儿之所以移植成功率高,有一项重要的检测技术pgd/pgs/技术���,还有一种就是ACGH技术�,可以通过胚胎活检筛选出健康胚胎���,从而选择健康胚胎移植成功的目的�。那么很多人会问�����,胚胎拿出去检测会影响胚胎的质量吗��,胚胎安全吗��?
什么是滋养外胚层活检
囊胚由两种不同的细胞类型组成����,即内细胞团(ICM)和滋养外胚层���。ICM细胞会发育成胎儿���,而滋养外胚层细胞则将继续发育成胎盘胚胎侧的胚胎细胞�。美国试管婴儿滋养外胚层活检���,就是从囊胚的滋养层中取出一小组细胞进行活体检查(通常5到10个)����。取出的细胞可以用于全面染色体筛?��。–CS)或进行特定的遗传性疾病测试��。
什么是卵裂球活检�?
在美国试管婴儿过程中�,当胚胎发展到卵裂阶段的第三天。含有6至8个细胞的胚胎可以用来做活体检查�����。每个细胞被称为卵裂球���。在胚胎卵裂阶段移出1或2个细胞可用来完成CCS或植入前遗传学诊断����。
囊胚期的胚胎如何ACGH检查
从胚泡中除去滋养外胚层细胞,然后通过全基因组扩增(WGA)提取并增加DNA�。 对于CCS-PGS,使用新一代基因测序(NGS)或阵列CGH测试遗传物质���。对具有染色体结构异常的夫妇��,使用aCGH检查不平衡的胚胎�。如果夫妇携带或受单基因疾病影响����, 将进行植入前遗传诊断以鉴定用于转移的未受影响的胚胎。
胚胎活检和PGD/PGS/ACGH安全吗?
可以肯定的说美国试管婴儿胚胎活检和PGD/PGS/ACGH都是安全的��。测试数据表明�,滋养外胚层活检的优势和ACGH并不会导致婴儿先天缺陷率的上升。用微阵列测试过染色体的胚胎�����,会排除染色体异常的妊娠�,因为大多数染色体异常的胚胎在移植到子宫前就被识别出了����。在胚胎发育早期取出几个细胞并不会影响胚胎发育成完整的���、正常妊娠的能力。

